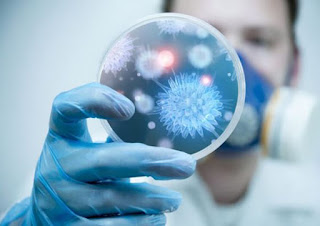

Η ανησυχία των ειδικών για τα μεταλλαγμένα κρούσματα κορονοϊού μπορεί να οδηγήσει σε μεγαλύτερη παράταση των μέτρων του lockdown
Μεγάλη είναι η ανησυχία των ειδικών λοιμωξιολόγων για τα κρούσματα του μεταλλαγμένου στελέχους κορονοϊού που εντοπίζονται στη χώρα μας. Συγκεκριμένα, έχουν εντοπιστεί 59 κρούσματα με το μεταλλαγμένο στέλεχος της Μεγάλης Βρετανίας, ενώ εξετάζονται ακόμα 3 ως ύποπτα μεταλλαγμένα κρούσματα στη Βόρεια Ελλάδα. Σημειώνεται ότι η πλειοψηφία των μεταλλαγμένων κρουσμάτων μέχρι στιγμής είχαν βρεθεί σε Αθήνα και Κρήτη.
Σύμφωνα με τον Παναγιώτη Αρκουμανέα, ο μεταλλαγμένος κορονοϊός από τη Μεγάλη Βρετανία είναι περισσότερο μεταδοτική, σε ποσοστό τουλάχιστον κατά 50%», γεγονός που θέτει σε επιφυλακή τους ειδικούς, που βρίσκονται εν αναμονή των νέων στοιχείων από την παγκόσμια κοινότητα.
Ο κ. Αρκουμανέας μιλώντας στον ΣΚΑΙ σημείωσε ότι ενδεχομένως το μεταλλαγμένο στέλεχος να επηρεάσει και τις αποφάσεις που παίρνουμε για τα μέτρα στην Ελλάδα και κάλεσε τους πολίτες να είναι σε εγρήγορση για την μετάλλαξη του ιού. «Πιστεύω ότι για κάποιο διάστημα θα πάμε με τα σχολεία. Αυτή την στιγμή δεν νομίζω ότι υπάρχει ένδειξη να ανοίξει κάτι άλλο», ξεκαθάρισε.
Η αγωνία των ειδικών
Νωρίτερα την Τρίτη 26 Ιανουαρίου, ο καθηγητής Χαράλαμπος Γώγος μίλησε στο OPEN TV και αναφέρθηκε και στις μεταλλάξεις του κορονοϊού, σημειώνοντας πως είναι περισσότερο μεταδοτική η μετάλλαξη του Ηνωμένου Βασιλείου. Παράλληλα, σημείωσε πως οι μάσκες FFP2 είναι πιο αποτελεσματικές αλλά πως και οι υφασμάτινες με τρεις στρώσεις και οι χειρουργικές μάσκες μπορούν να προφυλάξουν. Διευκρίνισε, ωστόσο, πως οι υφασμάτινες είναι χρήσιμες στην καθημερινότητα κυρίως όταν είμαστε σε εξωτερικούς χώρους.
Από την πλευρά του ο καθηγητής Μικροβιολογίας Αλκιβιάδης Βατόπουλος, μιλώντας στον ΣΚΑΙ για τις μεταλλάξεις σημείωσε: «Εχουν αρχίσει και εντοπίζονται μεταλλάξεις, όπως αυτή η βρετανική, της Βραζιλίας, της Νοτίου Αμερικής, οι οποίες όντως επηρεάζουν την επιδημιολογία του νοσήματος. Δηλαδή με απλά λόγια φαίνεται ότι γίνεται λίγο πιο μεταδοτικός».
Δεν αποκλείεται το ενδεχόμενο ενός τρίτου lockdown
Στην περίπτωση πάντως που ξεκινήσει μία εκθετική αύξηση των νέων κρουσμάτων και των εισαγωγών στα νοσοκομεία, οι ειδικοί της επιτροπής είναι έτοιμοι να «πατήσουν τη σκανδάλη» για νέο πιο αυστηρό lockdown. Σε πρώτη φάση πάντως ο σχεδιασμός τόσο των κυβερνητικών στελεχών όσο και των ειδικών είναι να ξεκινήσει ένα σταδιακό κλείσιμο της χώρας ανάλογα με την επιβάρυνση που επιφέρει η κάθε δραστηριότητα, περιγράφουν υψηλόβαθμες κυβερνητικές πηγές στο ethnos.gr. Τα σχολεία πάντως εφόσον ανοίξουν με βάση το σχέδιο την 1η Φεβρουαρίου, θα είναι και τα τελευταία που θα κλείσουν καθώς οι επιστήμονες εξακολουθούν να θεωρούν πως οι μαθητές επιβαρύνουν στατιστικά λιγότερο την επιδημιολογική εικόνα της χώρας, σε σύγκριση με άλλους τομείς.
Ο κύριος Βατόπουλος δεν απέκλεισε το ενδεχόμενο να τρίτου lockdown αλλά τόνισε ότι «δεν είναι κάτι που είναι άμεσο». Παράλληλα, εξήγησε ότι είναι εξαιρετικά πιθανόν η μετάλλαξη να επικρατήσει του αρχικού στελέχους καθώς φαίνεται πως μεταδίδεται πιο εύκολα και πως είναι εξαιρετικά σημαντικό πια να υπάρξει γρήγορος εμβολιασμός του πληθυσμού.
Το 3ο κύμα
Ταυτόχρονα οι ειδικοί ανησυχούν πως από την απελευθέρωση που καταγράφεται τα τελευταία 24ωρα στους δρόμους αλλά και στα εμπορικά καταστήματα, μπορεί να οδηγηθούμε γρήγορα στο 3ο κύμα της επιδημίας στην χώρα μας. Άλλωστε οι περισσότερες ευρωπαϊκές χώρες βρίσκονται ήδη στο 3ο κύμα και ζουν και πάλι μέρες αυστηρών lockdown.
Γι αυτό και ήδη έχει ξεκινήσει η προετοιμασία του ΕΣΥ με νέο επιχειρησιακό σχέδιο όπως αποκάλυψε το ethnos.gr. Το σχέδιο περιλαμβάνει ετοιμότητα στα νοσοκομεία ώστε να μπορούν και πάλι να ανταπεξέλθουν σε ένα νέο πιθανό κύμα. Πάντως υπάρχουν ειδικοί στην επιτροπή αλλά και άλλοι επιστήμονες που συνομιλούν με το Μέγαρο Μαξίμου, που εκτιμούν ότι τον Μάρτιο μπορεί να δούμε μεγάλη αύξηση των κρουσμάτων που μπορεί να φέρει για άλλη μία φορά τη χώρα σε ασφυκτικές καταστάσεις.
Καμπανάκι για την αποφυγή ενός πισωγυρισμάτος, ειδικά μετά τις μεταλλάξεις του κορονοϊού έκρουσε και ο κυβερνητικός εκπρόσωπος Χρήστος Ταραντίλης κατά τη διάρκεια της ενημέρωσης των δημοσιογράφων τη Δευτέρα 26 Ιανουαρίου. «Απαιτείται μεγάλη προσοχή και σχολαστική τήρηση των μέτρων ατομικής και συλλογικής προστασίας από όλες και όλους μας. Αν δεν προσέξουμε μπορεί πολύ γρήγορα τα δεδομένα να ανατραπούν», τόνισε χαρακτηριστικά κάνοντας ειδική μνεία στις νέες μεταλλάξεις
Πηγή: ethnos.gr